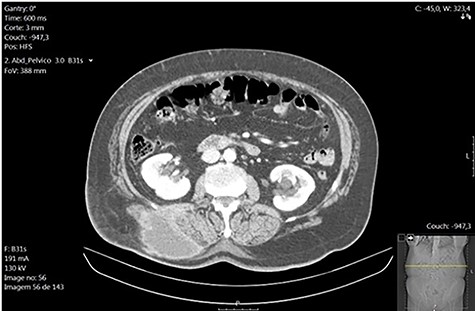
Right lumbar subcutaneous abscess (CT scan).

-
PDF
- Split View
-
Views
-
Cite
Cite
André Marçal, Ricardo Vaz Pereira, Ana Monteiro, José Dias, António Oliveira, João Pinto-de-Sousa, Right lumbar abscess containing a gallstone—an unexpected late complication of laparoscopic cholecystectomy, Journal of Surgical Case Reports, Volume 2020, Issue 7, July 2020, rjaa248, https://doi.org/10.1093/jscr/rjaa248
Close - Share Icon Share
Abstract
During laparoscopic cholecystectomy, gallbladder perforation may occur leading to gallstone spillage and despite being rare, early or late complications may therefore develop. We report a case of a 79-year-old female, with a past medical history of a laparoscopic cholecystectomy 3 years earlier for symptomatic gallstones, admitted in the emergency department with a subcutaneous right lumbar abscess confirmed by computed tomography. Emergent abscess surgical drainage was performed and a gallstone was identified during saline lavage. Postoperative evolution was unremarkable and follow-up within a year was uneventful. Split gallstones due to gallbladder perforation during laparoscopic cholecystectomy should be retrieved in order to reduce future complications.
INTRODUCTION
Nowadays, laparoscopic cholecystectomy is the treatment of choice for symptomatic gallstones. Compared to open surgery, it is associated with reduced morbidity and mortality, more rapid return to work, shorter hospital stay and reduced hospital costs. Postoperative pain is also lower and cosmetic results are better [1, 2]. This change of practice seems to be associated to higher incidence of iatrogenic lesions such as bile duct injuries and intraoperative spillage of gallstones. Gallstone spillage due to iatrogenic perforation of the gallbladder is common, varying between 6% and 40%, but its resulting complications are unusual [3–5]. We report a case of a lumbar abscess due to spilt gallstones occurring 3 years after laparoscopic cholecystectomy.
CASE REPORT
A 79-year-old woman presented in the emergency department with a painful right lumbar mass which had been increasing over the previous month. She denied fever, gastrointestinal and urinary symptoms or any recent trauma. Physical examination revealed a 10-cm long tender right lumbar lump with inflammatory signs suggesting to be an abscess. Laboratory investigations revealed a normal white blood cell count (9100/μl; segmented neutrophils, 68.0%), a hemoglobin level of 14.24 g/dl, an elevated C-reactive protein level (5.70 mg/dl) and normal hepatic and renal biochemical parameters. Computed tomography was performed which detected a well-defined collection of the subcutaneous tissue with 8.2 × 5.3 × 6.8 cm, with no retroperitoneal extension or renal involvement (Fig. 1). The patient had no relevant past medical history besides an elective laparoscopic cholecystectomy for symptomatic gallstones 3 years earlier. The operative report documented the procedure as ordinary except for gallbladder perforation with spillage of bile and gallstones into the peritoneum. No early or late complications were associated with the procedure and the anatomopathological examination showed chronic cholecystitis. A provisional diagnosis of a right lumbar subcutaneous abscess requiring surgical drainage was initially made and the patient was taken to the operating theater to go through the procedure. Under general anesthesia, an incision over the lump was performed with immediate pus output confirming the diagnosis. During saline lavage of the cavity, a 5-mm solid greenish foreign body was detected, suspected to be a gallstone (Fig. 2). The patient was discharged on postoperative day 2 on oral antibiotics. The anatomopathological examination of the foreign body confirmed to be a gallstone and follow-up within a year was uneventful.

DISCUSSION
Laparoscopic cholecystectomy was introduced in the 1980s, and it is the gold standard to treat symptomatic gallstones and its benefits over the open approach concerning cosmetic result, postoperative pain, hospital stay, morbidity and mortality are well established [1, 2]. After the emergence of the laparoscopic technique, two complications are more frequent: injury to the common bile duct, which is a rare event, and gallstone spillage occurring due to gallbladder iatrogenic perforation. The perforations may occur during the vesicular bed dissection, during the extraction of the gallbladder through the abdominal wall or because of gallbladder retraction needed for anatomic exposure, and it is as high as 40% [6, 7].
Complications caused by intraperitoneal gallstones are very rare but may occur, especially those related to pigment stones, large solitary stones (1.5 cm) or multiple small stones [6, 8]. According to the literature, they can occur soon after the surgery or up to 20 years later [9].
The most frequently reported complications are abscess formation related. Intra-abdominal is the most common site, typically subhepatic or subphrenic, but they have already been found in unusual peritoneal anatomic regions, such as the pelvis, paracolic, ovary, uterine tubes or in a hernia sac. The pneumoperitoneum and the peritoneal irrigation used during the cholecystectomy may contribute to the dispersion of the stones within the peritoneal cavity [3, 10]. As in the present case, migration of the stones may occur, forming distant abscesses, such as in the anterior or posterior abdominal wall and the retroperitoneal space. Migration into the pleural cavity has also been reported leading to pleurolithiasis, empyema and hemoptysis [10]. Other rare complications are related to septic shock [7].
An endeavor should be made to avoid gallbladder perforation, applying gentle dissection and identification of all the surrounding anatomy. Retrieval bags should be used to also avoid contamination of the port site. In the unfortunate event of gallbladder perforation, every possible effort should be made to retrieve the spilt gallstones. Conversion to open surgery is controversial, but due to the low incidence of postoperative complications, it is not advocated [3, 6, 7].
CONCLUSION
Gallbladder perforation with gallstones spillage during laparoscopic cholecystectomy is frequent, but its resulting complications are rare and fortunately not severe. When they occur, they may manifest as an abscess which can appear years after the initial procedure. An effort should be made to retrieve all the spilt stones, but those suspected to remain intra-abdominal should always be described in the operative report to elucidate future evaluation. Conversion to laparotomy for stone retrieval is not justified because the incidence of complications is low.